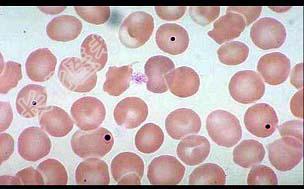

试题详情
- 多项选择题如图所示的异常红细胞结构可见于下列哪些疾病 ( )
A、溶血性贫血
B、巨幼红细胞性贫血
C、脾切除术后
D、铅中毒
E、缺铁性贫血
关注下方微信公众号,搜题查看答案

热门试题
- 下列哪项不是血红蛋白肽链结构 (
- 不符合原红细胞特点的是A、胞核大,呈圆形
- 下列哪项叙述不符合原粒细胞在透射电镜下的
- 中性粒细胞中的颗粒在生长过程中受阻或发生
- 染色血涂片中靶形红细胞增多见于A、失血性
- 珠蛋白合成异常的检验有( )A、异丙醇
- 血清结合珠蛋白测定,下列不正确的是(
- 下列除哪项外,均常出现于增生性贫血的血象
- 下列不是原始粒细胞和原始红细胞相似之处的
- 下列哪项叙述不符合透射电镜下的Auer小
- 关于血细胞发育过程中血细胞形态演变的规律
- 染色质超微结构中的异染色质,下列描述不正
- 下列哪项不符合原始红细胞在透射电镜下的结
- 下列符合早幼粒巴细胞形态特征的是( )
- 下列哪项不符合中性分叶核粒细胞在透射电镜
- 不符合原红的特点的是A、胞体大,可见突起
- 血小板内不存在的是A、A颗粒B、α-颗粒
- 患者,女性, 25岁,被诊断为缺铁性贫血
- 正常血细胞PAS反应,下列何者不正确A、
- 在透射电镜下,AML与ALL有关胞核的比